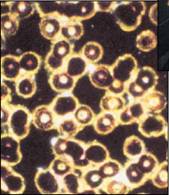

|
Dänische Bakterien-Heilkräuter-Substanz. VitaBiosa ist eine Mischung aus verschiedenen Mikroorganismen und Zuckerrohrmelasse fermentiert mit aromatischen Heilkräutern. Es beinhaltet Mineralien, Vitamine, Antioxidantien, Enzyme, Aminosäuren und weitere bioaktive Substanzen. VitaBiosa baut die Darmflora wieder auf und verhindert somit Verstopfung und die Bildung von Giftstoffen. Das Darm-Milieu wird entsäuert und in den gesunden basischen Bereich zurückgeführt. Die Mikroorganismen sorgen für ein gesundes Gleichgewicht im Darm und für ein besseres ‚Innenklima' im Körper. Antioxidantien eliminieren die freien Radikalen im Körper. |
|
VitaBiosa 1 L Flasche |
Mikroorganismen, die die Selbstheilungskräfte mobilisieren |
|
VitaBiosa ist im Humanbereich (EWG-Nr. 4437) als Nahrungsprodukt zugelassen, als eine Mischung aus aromatischen Kräutern und anderen Pflanzen, fermentiert mit einer besonderen Mischung aus Milchsäure- und Hefebakterien. Durch die Milchsäure entsteht während des Fermentierungsvorgangs ein niedriger pH-Wert von etwa 3,5. Der niedrige pH-Wert verhindert die Entwicklung schädlicher Bakterien im fertigen Getränk. Dreifache Wirkung Ein gesunder Darm ist die Wurzel menschlicher Gesundheit. Anwendung von VitaBiosa Die Erfolgsgeschichte der dänischen Bakterien-Heilkräuter-Substanz. Als in den 90er-Jahren der dänische Tierarzt Vagn Baastrup, der an Kachexie (Auszehrung) litt, in seiner Verzweiflung ein Mittel ausprobierte, das er normalerweise nur Kühen verordnete, geschah etwas sehr Unerwartetes. Der Tierarzt, der von seinen Ärzten als austherapiert nach Hause entlassen wurde, wurde wieder gesund. Die norwegische Familienzeitschrift "Hjemmet" berichtete über den Fall und läutete damit eine Erfolgsgeschichte sondersgleichen ein. Hier die deutsche Übersetzung des Berichts aus der norwegischen Familienzeitschrift "Hjemmet" (Daheim), der unter der Überschrift "Medizin für Kühe hat mein Leben gerettet" erschien: 1985 kam Vagn Baastrup in die Intensivabteilung ins Krankenhaus. Er hatte 25 kg abgenommen und war nur noch "ein langer Pfahl mit Haut rundherum", wie er selbst sagt. "Die Ärzte haben viele Untersuchungen gemacht und fanden heraus, dass ich eine chronisch entzündete Bauchspeicheldrüse hatte. Ich bekam ein Arsenal von Medizin, aber davon wurde mir nur noch schlechter. Und nichts davon hat geholfen. Nach vielem Probieren habe ich sie schließlich weggeworfen und nichts mehr eingenommen. 1996 haben mich die Ärzte aufgegeben. Sie hatten keine Medizin ehr anzubieten und haben mich gebeten, nach Hause zu gehen, um praktische Dinge zu erledigen, wie zum Beispiel ein Testament schreiben. Ich kam nach Hause zu meiner Frau und meinem Sohn, um sie und mich darauf vorzubereiten, dass ich bald sterben würde", erzählt Vagn Baastrup. "Ich überlebte wider Erwarten" Vagn hatte große Schmerzen und verlor noch mehr an Gewicht. Aber er hielt sich wie durch ein Wunder am Leben. Inzwischen hatte sich 1999 die Situation radikal verschlechtert und Vagn kam wieder ins Krankenhaus. Diesmal wurde er nach Hause geschickt mit einer Tasche voll Morphium, das er nehmen sollte, um die schlimmsten Schmerzen zu betäuben in der letzten Phase seines Lebens. "Ich war nicht länger ein Mensch, nur noch ein Zombie. Ich überlebte, auch wenn die Chancen sehr gering waren", sagt der pensionierte Tierarzt und zeigt einen Brief, den er vom Krankenhaus mitbekommen hatte. Ein Brief mit seinem Todesurteil. Plötzlich reißt er den Brief in zwei Stücke "Ich bin jetzt gesund und munter! Was soll ich denn jetzt mit diese üblen Stück Papier? VitaBiosa vier mal täglich Wenn man wie Vagn Tierarzt ist, kennt man sich gut mit großen und kleinen Tieren aus. Für Vagn waren aber Mikroorganismen etwas Neues zumindest in dem Zusammenhang, den er zwei Jahre zuvor durch einen Artikel in der dänischen Tageszeitung Aarhus Stiftstidende erfahren hatte. Die Zeitung schrieb damals über die Technologie der Natur, über Mikroorganismen, die in der Lage seien, viele Gifte und Medikamente, die in der Landwirtschaft sowohl für Tiere als auch für Pflanzen verwendet werden, aufzulösen und unschädlich machen zu können. Der Artikel berichtete über einen Kuhbestand in Randers, der so krank war, dass der Bauer weder die Milch noch das Fleisch verkaufen konnte. Der Bauer bespritzte dann das Vieh, das Futter und den Stall mit ausgewählten VitaBiosa Mikroorganismen und in kurzer Zeit wurden die Kühe gesund. Die Natur hatte der Natur geholfen! Vagn: "Als ich als Tierarzt gearbeitet habe, war ich besonders interessiert an Bakteriologie und der Inhalt des Artikels überzeugte mich. Wenn Mikroorganismen bei Infektionen den Kühen helfen konnten, warum sollten sie nicht auch Menschen helfen können? Man kann alle Tiere von der Erde entfernen und die Mikroorganismen werden weiter überleben. Aber entfernt man die Mikroorganismen, werden die Tiere und alles Leben auf der Erde sterben. Diese Mikroorganismen haben also eine (über)lebensnotwendige Aufgabe und ich fühlte instinktiv, dass diese Organismen auch mir helfen könnten. Er erkundete sich, wo diese effektiven Mikroorganismen gekauft werden konnten und bestellte dann mehrere Liter davon. "lch begann mit einer niedrigen Dosis für einige Wochen und änderte dann die Einnahmemenge nach eigenem Gutdünken bis auf 25 Milliliter vier mal täglich. Und dann begann sich etwas zu regen, kann ich sagen! Es polterte in mir. Es fühlte sich an, als ob eine Flaschenbürste durch das ganze Darmsystem gedrückt wurde. Und gleichzeitig fühlte ich, dass eine Energie zurückkam. Ich konnte die Einnahme von Morphium schnell reduzieren und nahm ausschließlich Mikroorganismen. Das Gewicht nahm wieder zu. Der Durchfall, den ich 15 Jahre lang hatte, blieb weg. Ich konnte das Essen wieder vertragen. Die Schmerzen verschwanden. Eine positive Sache nach der anderen geschah. Und das ist alles im Laufe von anderthalb Monaten geschehen". Die Zeitung schrieb damals über die Technologie der Natur, über Mikroorganismen, die in der Lage seien, viele Gifte und Medikamente, die in der Landwirtschaft sowohl für Tiere als auch für Pflanzen verwendet werden, aufzulösen und unschädlich machen zu können. Der Artikel berichtete über einen Kuhbestand in Randers, der so krank war, dass der Bauer weder die Milch noch das Fleisch verkaufen konnte. Der Bauer bespritzte dann das Vieh, das Futter und den Stall mit ausgewählten VitaBiosa Mikroorganismen und in kurzer Zeit wurden die Kühe gesund. Die Natur hatte der Natur geholfen! Vagn: "Als ich als Tierarzt gearbeitet habe, war ich besonders interessiert an Bakteriologie und der Inhalt des Artikels überzeugte mich. Wenn Mikroorganismen bei Infektionen den Kühen helfen konnten, warum sollten sie nicht auch Menschen helfen können? Man kann alle Tiere von der Erde entfernen und die Mikroorganismen werden weiter überleben. Aber entfernt man die Mikroorganismen, werden die Tiere und alles Leben auf der Erde sterben. Diese Mikroorganismen haben also eine (über)lebensnotwendige Aufgabe und ich fühlte instinktiv, dass diese Organismen auch mir helfen könnten. Er erkundete sich, wo diese effektiven Mikroorganismen gekauft werden konnten und bestellte dann mehrere Liter davon. "lch begann mit einer niedrigen Dosis für einige Wochen und änderte dann die Einnahmemenge nach eigenem Gutdünken bis auf 25 Milliliter vier mal täglich. Und dann begann sich etwas zu regen, kann ich sagen! Es polterte in mir. Es fühlte sich an, als ob eine Flaschenbürste durch das ganze Darmsystem gedrückt wurde. Und gleichzeitig fühlte ich, dass eine Energie zurückkam. Ich konnte die Einnahme von Morphium schnell reduzieren und nahm ausschließlich Mikroorganismen. Das Gewicht nahm wieder zu. Der Durchfall, den ich 15 Jahre lang hatte, blieb weg. Ich konnte das Essen wieder vertragen. Die Schmerzen verschwanden. Eine positive Sache nach der anderen geschah. Und das ist alles im Laufe von anderthalb Monaten geschehen". Der Arzt hat einen Schock bekommen Im November 1999 wurde Vagn zur Nachuntersuchung ins Krankenhaus eingeladen. Da hatte er bereits die Mikroorganismen jeden Tag zwei Monate lang getrunken. Sein Arzt im Aarhuser Krankenhaus bekam einen Schock, als er den Patienten wieder sah. Was war geschehen? "Ich sagte, dass ich meine Medizin geändert hätte. Und ich hätte herausgefunden, dass die Technologie der Natur eine viel bessere Arbeit leistet als die Medizin der Wissenschaftler. Hierfür wollte der Arzt einen Beweis haben, also musste ich einige Tage später wieder kommen, um eine Menge Proben machen zu lassen. Vier Tage vergingen - dann rief der Arzt mich an: "Du kannst dich wieder als Soldat anmelden! Alle Proben, die wir genommen haben, sind 100% positiv. Es fehlt dir nichts!" Der Arzt schrie fast ins Telefon. Er war mindestens genauso froh wie ich es war", sagt Vagn. 8000 Anfragen Jetzt war Vagn an der Reihe, der Zeitung Aarhus Stiftsidende zu berichten, eine Zeitung, die in Jütland sehr verbreitet ist. Er erzählte seine Geschichte und der Ball kam ins Rollen. Alle wollten mit Vagn reden. War es wirklich wahr, was er da erzählte? War da auch Hoffnung für andere Leiden? Vagn bringt ein Paar Notizbücher hervor. Die Hälfte davon enthält Namen und Telefonnummern, aber dann werden es nur noch Namen und zuletzt nur noch Strichlisten und noch mehr Strichlisten. Zwei Bücher voll! "Ich gab es auf, die Namen nach jeder Anfrage aufzuschreiben. Das Telefon klingelte Tag und Nacht und es klingelt weiterhin", sagt er. Bisher haben mindestens 8000 Dänen den pensionierten Tierarzt angerufen und ihn um Rat gebeten. Gut 2000 davon haben zurückgerufen mit positiven Rückmeldungen, dass die Mikroorganismen ihnen geholfen haben. Ein fleißiger Rentner Vagn hat schnell herausgefunden, dass er wieder gebraucht wurde. Er ging eine Vereinbarung mit der Firma ein, die diese Mikroorganismen produziert. Er erhielt eine größere Menge des Produktes, damit er es an diejenigen weiter geben konnte, die anriefen und um Hilfe baten. "15 Jahre lang war ich dem Tode nahe und das war wahrlich kein Vergnügen, kann ich sagen. Wenn ich nun anderen helfen kann , tue ich es gerne. Jetzt bin ich Rentner, aber ich mag es immer noch, mich mit meinen Brieftauben zu beschäftigen. Auch sie bekommen einen täglichen Schluck Mikroorganismen. Keiner verlässt mein Haus, ohne ein Glas VitaBiosa zu bekommen." "Auf welche Erkrankungen hast du positive Rückmeldungen bekommen?" "Es sind viele. Ich bin angerufen worden von Hunderten von Menschen, die Hilfe für unzählige Darmleiden gefunden haben, besonders Morbus Crohn, aber auch andere Dünndarmentzündungen. Ansonsten kann ich Pilzinfektionen der Bronchien nennen, Migräne, Prostataleiden, Angina-Beschwerden, Candida, Psoriasis, Nebenhöhlenentzündungen und FibromyaIgie" zählt Vagn auf. Dann holt er tief Luft und berichtet weiter: "Außerdem weiß ich von HIV-Positiven, die eine viel bessere Lebensqualität bekommen haben. Zu früh geborene Säuglinge entwickeln sich schneller und nehmen schneller zu, wenn sie gestillt werden und die Mutter gleichzeitig Mikroorganismen einnimmt. Menschen mit Amalgamvergiftungen und Gelenkgicht geht es viel besser und auch andere Arten von Schmerzsyndromen werden stark reduziert, manchmal bis zu 90%. Nein, alles kann ich nicht wissen. Ich sage lieber: Probiert es selbst aus!" Auch Ärzte trinken diese Mikroorganismen Ärzte in ganz Jütland sind definitiv über das "Phänomen Vagn Baastrup" informiert worden. Einer nach dem anderen ist bei ihm zu Hause gewesen. Andere Ärzte sitzen zusammen in Gruppen und diskutieren über "den Mann, der nicht sterben wollte", und sie haben auch die Mikroorganismen im Labor unter die Lupe genommen. Es wird diskutiert, getuschelt und gemunkelt. "Ich bin überzeugt, dass effektive Mikroorganismen bald auch in der SchuImedizin verwendet werden. Die Ärzte, mit denen ich gesprochen habe, geben zu, dass da etwas faul ist, kranken Menschen Medizin zu geben, die die Krankheit verschlimmern, statt sie zu verbessern. Auch deshalb kaufen sie Mikroorganismen und geben sie weiter an ihre Patienten. Ein Arzt aus Vejle kam neulich zu mir. Er nahm sich viel Zeit, um mit mir zu sprechen nd bestellte dann 25 Liter für seine Großmutter. Es sind Tausende von Litern, die ich bis jetzt in ganz Dänemark vermittelt habe. Und zu Tausenden sind die Dänen ihre Leiden entweder losgeworden oder sie haben Linderung gefunden", sagt der pensionierte Tierarzt.
Gefährliche Oxidationsprozesse Oxidationsprozesse von freien Radikalen können im Körper und Krankheiten auslösen. Bei der Durchführung einer Antioxidationskur wird besonders der Verzehr von Vollreis (= brauner Reis), Gemüse und Seetang, die antioxidantive Wirkungen haben, empfohlen. Dazu die Einnahme des Gärproduktes zur Erhaltung einer guten Gesundheit. Es ist bemerkenswert, dass Vollreis im Vergleich zu Vollweizen oder anderen Getreidearten eine starke Antioxidationswirkung hat. Insbesondere enthält der Reiskeim viele antioxidatischen Substanzen und Vitamine. Seine Außenschicht besteht aus diätetisch wichtigen Fasern. Durch Verzehr solcher diätetisch wirksamer Fasern vermehren sich nützliche Mikroorganismen im Darm, wogegen schädliche Keime in der Entwicklung gehemmt werden. Diese Fasern verbinden sich mit radioaktiven Substanzen, mit Schwermetallen, Chemikalien und Cholesterol und scheiden sie aus. Solche Faserballaststoffe regulieren den Kontakt der Darmschleimhäute mit karzinogenen Substanzen. Auch im Gemüse sind viele antioxidante Substanzen und Vitamine enthalten. Vergleicht man allerdings die Inhaltstoffe von organisch und chemisch angebautem Gemüse, so hat ersteres mehr Vitamine und Mineralien und infolgedessen mehr Antioxidantien vor allem wenn sie mit Biosa Produkten behandelt werden. Die im Körper entstehenden "freien" Radikale (d.h. aktiver Sauerstoff) lassen Lipide oxidieren, Eiweiße degenerieren, Enzyme inaktiv werden und Nukleinsäuren zerfallen. Diese Veränderungen sind es, die zu Krankheiten und vorzeitigem Altern führen |
|
VitaBiosa - Mikroorganismen, die der Gesundheit helfen können |

|
Der Tierarzt Vagn Baastrup, den VitaBiosa vor dem sicheren Tod rettete. |
|
Mit Hilfe der Dunkelfeld-Mikroskopie nach Brehmer kann man die Wirkung der Mikroorganismen schon wenige Minuten nach der Einnahme beobachten. Diese Dunkelfeld-Abbildung ( hier in der Abbildung jedoch ohne Einnahme von VitaBiosa) zeigt stärker befallenes Blut – sichtbar an der unter-schiedlichen Größe der Erythrozyten. Teilweise sind Dellen gesprengt, teilweise sind sie vollgestopft mit Sporen und Sporangien. Auch das Plasma ist stärker belastet. |

|
Der dänische Radio- und TV -Arzt Carsten Vagn- Hansen empfiehlt VitaBiosa seinen Hörern und Fernsehschauern |
|
energetische Lichtarbeit |

